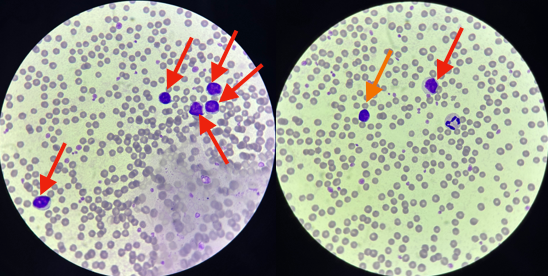

獣医師の渡邉佳和子です。
今回は大変興味深い症例について、皆さんにご紹介したいと思います。
今回の稟告は「乳量低下」のみ、初診日に行ったのは血液検査、直腸検査と点滴治療のみでした。
しかし、往診後の血液検査でBUN・Creの異常な上昇が見られたことをきっかけに翌日追加で検査を行い、ある一つの可能性が非常に強く疑われた症例です。
以下の文章は、各種検査の結果をまとめ、そこから推測される牛の予後について農家さんにお知らせしたレポートに部分的に追記したものとなります。
はじめに
-初診時の状態
T:37.9→低体温 P:108 R:36 心音、肺音に異常なし
右前肢の痛みあり、起立可能だが時間かかる、起立時間短い
脱水・貧血症状なし
胃の動きなし、便質正常だが非常に少ない、皮温・耳介温低下→低Ca疑う
ピング音・拍水音なし
直腸越しに腫瘤触知→リンパ腫?翌日エコー検査実施へ
血液について
-初診日の血液検査結果

②:今回の最も重大なポイントです。BUN・Creは犬猫では腎機能障害が3/4程度まで失われないと明確に上昇しない数値ですが、いずれも基準値の3倍程度まで上昇しており、腎機能障害が強く疑われました。
BUN・Creの変化を以下の表に示します。
初診日からの約1週間で、BUN・Creともに急激に増加していることがわかります。

①③④:血糖値はやや上昇、Na・Clはやや低下、Caが中等度低下しており、軽度な消化管通過障害が疑われました。これに則するように、直腸内の便は非常に少なく、自然排便はほぼみられず、体温と皮温の低下が認められています。
⑤:本牛はBLV陽性牛であり、今回は牛伝染性リンパ腫と今回の病態の関連が強く示唆されています。ただし、機械を通した検査結果ではリンパ球の増加は確認されなかったため、血液塗沫を染色し、顕微鏡下で実際に白血球を数えてみました。
計数結果は以下の通りです。

血球カウント用のアプリのスクリーンショット画面です(顕微鏡を覗きながら、見えた血球の数だけ手で個数を打ち込んでいます)。
白血球200個中、リンパ球は182個となり、割合にして91%でした。
機械での測定結果とは矛盾しますが、肉眼で明らかにリンパ球が白血球の大半を占めていることが確認できました。
さらに、リンパ球が腫瘍性のものであるかどうかも確認しました。

低倍率像。
矢印で示した濃い紫色の点状に見えるのが白血球ですが、そのほとんどがリンパ球です。
高倍率像。
オレンジ色の矢印は正常リンパ球、赤色の矢印は腫瘍性リンパ球、矢印がないのは好中球です。視野に映る白血球のうち、大半が腫瘍性リンパ球であることがわかります。
尿について
血液検査から腎臓機能障害が強く疑われたため、尿に関する検査をいくつか行いました。
-現場での簡易検査

腎臓病の種類の鑑別ポイントとなる項目に関して、
・尿蛋白→なし:糸球体疾患は除外
・pH→正常:細菌性腎盂腎炎は除外
・尿比重→正常
・白血球→なし:非感染性/感染性の(腎盂)腎炎、膀胱炎、尿道炎は除外
・潜血→3+:炎症、結石、腫瘍などによる出血を示唆する
・自然排尿あり、量は正常
・排尿姿勢に異常なし

持ち帰った尿です。
蛋白尿を示唆する泡立ちはなく、目立った混濁や血尿も見られませんが…

尿を遠心分離機にかけてみると、5mm大の赤黒い沈渣が出現しました。
簡易検査で判明した潜血3+を証拠づける結果となりました。
この沈渣をそれぞれグラム染色(細菌を染める)・ギムザ染色(血球を染める)してみます。
尿沈渣の正体は、赤血球の塊である
=尿路のどこかで出血が発生しているが、尿が赤くなるほどではないことがわかりました。
現場での簡易検査で「潜血+++」だったことと一致する結果です。

グラム染色結果。
細菌性腎盂腎炎の原因としてほとんどを占めるコリネバクテリウム属菌(グラム陽性=紫色、松葉状桿菌)や大腸菌(グラム陰性=ピンク色、桿菌)は認められませんでした。

ギムザ染色結果。
尿沈渣の正体は、赤血球の塊である
=尿路のどこかで出血が発生しているが、尿が赤くなるほどではない
ことがわかりました。腎疾患において鑑別の要素となる尿円柱や白血球は混ざっていません。また、血色素尿ではなく血尿であることも明らかとなりました。
これらの各要素から、血液検査の結果だけでは判別できなかったいくつかの泌尿器系疾患を鑑別することができました。
大雑把にいうと、腎臓の病気が根本にあるわけではなく、何か他の病気が先にあって、それが尿路系~腎機能に障害をもたらしているという可能性、そしてその他の病気とはやはり牛伝染性リンパ腫(=腫瘍)である可能性が第一に挙げられました。
直腸検査について
初診時の直腸検査では、便が少ないこと・蠕動運動が少ないことのほかに、
リンパ腫と思われる腫瘤が骨盤腔内で触知されました。
左背側で20cm大棒状の腫瘤①、右背側で5cm大球状の腫瘤②が図の通り触知されました。また、左腎臓は通常の位置に触知されました。

この腫瘤が腎機能や尿路を物理的に障害し、軽度な出血を起こしているのでは?という推察のもと、超音波検査を行いました。
以下に撮影した画像を示します。

各断面図の位置を図示しています。


断面①
腎盂が拡張しています。右に示す他の牛と比較することでよくわかります。

断面②
通常であればエコーで映せないはずの尿管が内腔1cmまで拡張し、壁は肥厚しています。


断面③④
腫瘤①に巻き込まれた尿管は、断面②と比較すると押しつぶされるようにして狭窄しています。
以上の画像と触診から、腫瘤①が尿管を巻き込むように形成されており、巻き込まれた尿管は著しく狭窄し(③④)、腎盂および腫瘤より腎臓側の尿管は鬱滞した尿により著しく拡張している(①②)ことがわかりました。

図にするとこのような感じです。
腫瘤により行き止まりに近い状態となった尿管では尿が膀胱へ向かうことができず、腫瘤より腎臓側では作り続けられる尿がどんどん溜まっていき、腎盂と尿管を拡張させているという状況が予想されます。
ただし、右側の腎臓~尿管ではこのような状況に陥っていないため、排尿量は正常に見えるのだと予想されます。
この状態が続くと、腎盂はさらに拡張し、鬱滞した尿が腎臓実質を圧迫し、左腎機能が時間と共に失われていくことが予想されます。
そして、血液検査の結果からも推察される通り、やはりこの腫瘤①②の正体はリンパ腫であると考えられます。
尿管周囲の腫瘍はさらに浸潤・転移したり、腎臓自体が腫瘍化することも考えられます。
新たにできた腫瘤について
4診目の日、右下腹部の乳静脈付近に新たな腫瘤ができているのが確認されました。
動画(1)
クリックすると再生されます(19秒)
外から触ると波動感はありませんでした。
エコーで撮ってみます。


皮下に、白っぽく映る網目状の構造と、深部には高エコーの部分も見られます。
確実なことはこれだけでは言えませんが、乳静脈周囲にリンパ腫が形成されたのかも?という考えもよぎりました。
便について
初診時から排便量の減少が確認され、血液検査からは消化管通過障害も示唆された本牛の便質は、診療期間を通して以下のように変化しました。

3診目。量は少ないですが正常便です。

7診目。量はわずかで、黒っぽくべちゃっとした便に変化しています。消化管通過障害が強く疑われます。
今後について
現時点での問題:
①リンパ腫が尿路系周囲だけでなく腹腔内にもできているかもしれない
→消化管通過障害、採食急減の原因として第一に考えられますが、見ることも触ることもできないためあくまで推測です。
以下は、リンパ腫が腸管周囲に急激に形成されたことで食欲廃絶・腹囲膨満・排便停止を示し、短期間で死に至った過去の症例です。

全く同じ経過とは限りませんが、様々な要因により死に至る可能性が考えられます。
②左腎機能障害は元に戻ることはなく、今後進行していくと考えられる
→残っている右腎臓の機能でもう少し生きることはできるかもしれませんが、左腎臓の機能喪失は進行し続けるため、根本的な解決は見込めません。
③消化管通過障害や腎機能障害が現状レベルで維持されたとしても、結果としての低Caで起立不能に陥るかもしれない
→現在、本牛は脱水・低Ca状態に陥っており、その要因は消化管通過障害と腎機能障害であると考えています。
この状況は一時的に輸液療法で補正できますが、リンパ腫が物理的に消化管・尿路系を障害していた場合それを取り除くことはできないので、根本的な治療にはなり得ません。
消化管通過障害・腎機能障害は現時点では致死的なレベルではありませんが、これらによって引き起こされる低Caは起立不能をもたらす可能性があります。
各種検査の結果、「輸液療法で多少延命することはできるかもしれないが、根本的な改善や良好な予後は見込めない可能性が高い」ということが予想されています。
おわりに
以上のような内容を、第2診日の終わりに農家の方にお伝えしました。
初診日には点滴治療で若干採食量の回復は見られましたが根本治療は望めないため、翌日以降の治療は右前肢の痛みを抑えるための鎮痛剤投与のみとしました。
いかがでしょうか。大動物の診療現場では、小動物とは異なり検査方法や項目も限られてしまいますが、そのような中でもヒントを少しずつかき集めればここまで話を展開することができるということが伝わると幸いです。
今回もお読みくださりありがとうございました!





コメント